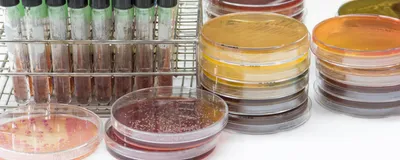
Photograph of bacterial cultures grown in test tubes and petri dishes on a laboratory bench

Reproducible results in bacterial culture depend on both proper technique and contamination control. Reliable and easy-to-clean pipettes, sterile filter tips, and consistent handling protocols help researchers maintain culture viability and integrity.
Download this guide to learn about
- Common causes and consequences of culture contamination
- Sterile handling techniques for pipettes and tips
- Tips for aseptic sampling and maintenance
- How to improve bacterial growth consistency